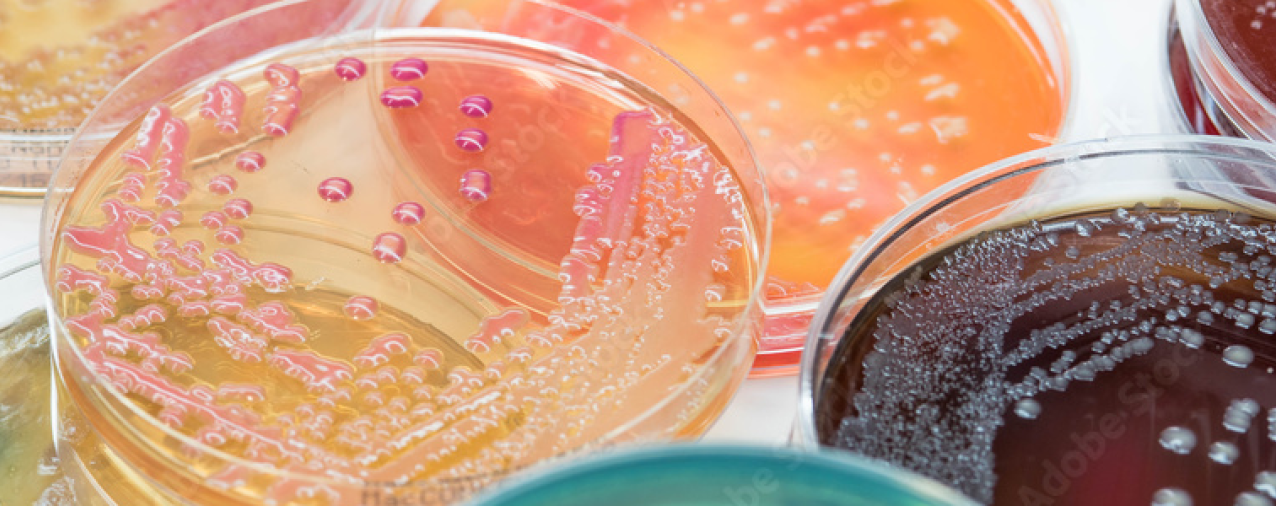

Genomics: Insight
Culturomics: Essentials to a Successful Bacterial Culture
Research Question: How can scientists systematically study the gut microbiome bacteria strains using culturomics and genomics?
Introduction
Genomics offers the ability to study microbial compositions, such as the human microbiome, and drive understanding of diseases such as diabetes, autoimmune disorders, and allergies. By enabling culture-independent methods to identify bacteria, genomics has expanded our understanding of microbiome composition. Key genomics techniques include metagenomics, the genetic study of entire communities of microorganisms, and 16S rRNA gene sequencing, which targets specific regions of the 16S rRNA gene to distinguish between bacterial taxa. Comparative genomics also allows for cross-species genome comparisons to understand evolutionary relationships, and many more techniques like metatranscriptomics enrich our bacteria knowledge.
The development of sequencing technologies enabled the discovery of new bacterial strains in the past twenty years, though most of these novel bacteria remain unculturable. To date, only about 2% of all discovered bacterial strains have been cultured in laboratory settings (Wade et.al., 2002). Yet, the culture of a target bacteria is essential to gain insights into their characteristics, study their susceptibility to antibiotics, research therapeutics applications, and ultimately understand the role they play in disease, all of which cannot be done by sequencing alone. To address limitations in culturability of novel bacteria, the field of culturomics was developed to tailor media compositions for supporting microbial growth.
Various techniques have been developed to optimize bacterial culture, which include media preparations, additional supplements, and thermal treatments to enhance bacterial growth. This paper reviews culture techniques from the past decade (2012 to 2023) and highlights the critical components contributing to successful bacterial culture, and how their genomic composition impacts their optimal conditions.
Key Culture Conditions
All bacteria require basic nutrients to grow: water, a carbon source, a nitrogen source. However, some bacteria require additional nutrients beyond this minimal medium to grow. Growth factors can be added to supplement metabolic pathways that a bacterium lacks or has blocked (Bonnet et.al., 2019). Table 1 below summarizes the common growth techniques across cultures.

1. Addition of animal contents (animal tissue, blood/rumen fluid contents)
A common feature among successful bacterial culture techniques is the addition of animal-derived components, such as blood, rumen fluid, or tissue, to the culture medium. This was observed in 80% of the analyzed studies (see “Animal Contents”, Table 1).
With over 99% of the gut microbiota being anaerobic bacteria, these bacteria often require enriched media to meet their nutritional needs and replicate the complex environment of the gut. Blood, which is rich in catalase, filtered rumen fluid, and animal tissues, are used to supply these elements. Typically, 5% blood is added to the culture media, with blood serum providing key elements such as lipids, vitamins, triglycerides, minerals, and others. Rumen fluid, extracted from the rumen of animals, is an additive that promotes general growth by mimicking the gut’s natural environment.
Animal tissue is also a valuable component in culture media. Meat, for instance, is rich in oxygen-reducing molecules such as cysteine, glutathione, and unsaturated fatty acids. These factors make a more anaerobic environment where oxygen is quickly consumed or reduced, which more closely mimics the natural human gut condition (Guilhot et.al., 2018).
2. Addition of other growth factors (soy, amino acids, casein)
In the absence of animal supplements, 100% of studies analyzed had incorporated alternate growth factors into their culture conditions. In addition to using standard agar, many studies utilized media such as YCFA Agar or Tryptic Soy Agar (both rich in casein), or Buffered Charcoal Yeast Extract (rich in amino acids), as well as additional growth factors to support bacterial growth (Table 1).
Growth factor supplements include casein, amino acids, antioxidants, and vitamins. Some bacterial species cannot synthesize all necessary amino acids and instead, require supplementation to grow effectively. Casein is a rich source of peptides, amino acids, and nitrogen, serving as essential nutrients for bacteria. Antioxidants are also added to the culture medium to allow the culture of strict anaerobic bacteria (Bonnet et.al., 2019). Furthermore, vitamins act as essential cofactors and coenzymes in metabolic pathways and are necessary for bacteria that cannot synthesize these nutrients.
Ultimately, genomics and their corresponding mechanisms must be analyzed to understand a bacteria’s ability to utilize different nutrients, and identify necessary growth factors for an optimal culture. Technologies such as the CAMII system leverages machine learning and genomics to systematically culture microbial strains—CAMII identifies protein-coding sequences of the most widespread horizontal gene transfer (HGT) signatures to probe their potential metabolic capabilities, which can inform media design for specific microbes (Huang et.al., 2023).
3. Selective agents
Selective culture agents are used to isolate specific bacterial species or genera by inhibiting growth of unwanted microbial flora and/or promoting target bacteria growth. These agents include antibiotics, chemicals, and salts, which can be added to modify the pH of the agar, among other factors, selecting against the growth of certain bacteria (Table 1). For instance, Skirrow’s Medium contains antibiotic-selective agents—polymyxin B and trimethoprim—that inhibit the growth of non-target bacteria while allowing Campylobacter species to thrive (Ito et.al., 2018).
Chemical substances and salts are effective in inhibiting the growth of unwanted bacteria. Potassium tellurite and bile salts, for instance, inhibit Gram-positive bacteria, while lithium chloride targets Gram-negative bacteria. Antibiotics are also among the most common selective agents. Specific antibiotics target Gram-positive bacteria—such as penicillin G, bacitracin, or vancomycin—while others, like colistin or polymyxin B, are effective against Gram-negative bacteria (Bonnet et.al., 2019).
Additionally, bacteria can be selected for via additives supporting target species. As shown in Table 1, the “Selective Agents/Additives” column displays a variety of agars tailored to culturing a species—Selenite Broth selected for Salmonella, and Bryant & Burkey Medium cultured Clostridium (Table 1). Because bacterial metabolic pathways and functions are unique to each species and phylum, their preferred growth factors differ. For example, BY Chocolate Agar, which contains lysed red blood cells, was used for the cultivation of Neisseria and Haemophilus species. MRS Agar, enriched with peptones, yeast extract, and glucose, is particularly suited for Lactobacillus species. On the other hand, CCFA agar contains fructose, which C. difficile ferments for a carbohydrate source, aiding in its specific growth (Ito et.al., 2018).
Like the choice of growth factors, the utilized selective agents depend on underlying genomics information—High-throughput microbial culturomics facilitates the detection of antibiotic resistance genes (ARGs) to inform the use of selective antibiotics when isolating target strains (Huang et.al., 2023).
4. Anaerobic culture at 37°C for 24-72h.
Most successful cultures were achieved through anaerobic culture at 37°C for 24 to 72 hours. All papers incubated bacteria at 37°C, with all but one incubating between 24 to 72 hours, and 80% of studies relied on anaerobic conditions (Table 1).
Anaerobic culturing is particularly effective because most bacterial species of the human gut flora are obligate anaerobes, making oxygen toxic to their survival and proliferation. Additionally, the widest range of human pathogens multiply best at temperatures that closely mimic the human body's natural conditions. Though most will reliably grow between 35°C and 37°C, colonies may require varied optimum temperatures (Gutierrez et.al., 2018). The incubation period of 24 to 72 hours captures most bacteria during their log and stationary growth phase. This timing ensures that cultures are studied when the bacteria are most metabolically active and abundant. However, this time window may be insufficient to observe the growth of some target bacterial strains, as seen by the culture requiring 5 days for observation (Lau et.al., 2016). Thus, detection of growth also depends on their starting inoculum size, slow growth rates under laboratory culture conditions, and sensitivity of detection tools.
5. Method for classifying bacteria
The methods for classifying bacteria have evolved significantly throughout the years. The earliest approaches relied primarily on the ability to culture in the presence of various media, and following methods introduced morphology—classification based on visible characteristics.
In the 1970s, methods for classifying bacteria transitioned to genomics technologies when Frederick Sanger developed 16S ribosomal RNA genetic sequencing. The 16S rRNA gene is highly conserved across different species, making it a reliable marker for differentiating bacteria at the species and genus levels. This transition from physical characteristics to genetic material provided a much more detailed understanding of bacterial phylogeny and remains a widely used method, as observed in 100% of analyzed studies (see “Classification”, Table 1).
Matrix-Assisted Laser Desorption/Ionization-Time of Flight (MALDI-TOF) mass spectrometry has emerged in 50% of studies as one of the most efficient techniques for identifying bacteria (see “Classification”, Table 1). The resulting peptide mass fingerprint from analyzing the protein profiles of MALDI-TOF is used to identify microbes by comparing them to reference database spectra (Singhal et.al., 2015).
Additionally, genomic related advances such as metagenomics, amplicon sequencing, and nucleic acid analysis technologies, provide many tools for culturomics and expanding the bacteria database. Nucleic acid analysis methods like polymerase chain reaction (PCR), Sanger sequencing, and CRISPR method, allow scientists to sequence nucleic acids from clinical samples, analyze and classify novel bacteria, and assemble the genomes.
Conclusion
Culturomics plays a crucial role in advancing our understanding of bacterial genomics, and genomics enhances our approach to culturomics. In this Review, ten relevant studies that sought to identify culture conditions that would enable the growth of previously-unculturable bacterial strains were compared. By creating a 37°C anaerobic culture environment supplemented with growth factors, while varying the additives and selective agents based on genomic analysis, many previously-uncultured bacteria were successfully cultured. The ability to culture these novel bacteria facilitates our understanding of the complex biological systems that affect us.
Despite its importance, culturomics remains underexplored in relation to genomics. Sequencing data has revealed that a substantial portion of the human microbiome is still unculturable, highlighting the need for additional methods. Through our continued efforts, we can enrich the bacterial repertoire and establish the causality of host-microbiome interaction, gaining a better understanding of diseases and targets for therapeutics.
"By creating a 37°C anaerobic culture environment supplemented with growth factors, while varying the additives and selective agents based on genomic analysis, many previously-uncultured bacteria were successfully cultured."
References
- Bonnet M, Lagier JC, Raoult D, Khelaifia S. Bacterial culture through selective and non-selective conditions: the evolution of culture media in clinical microbiology. New Microbes New Infect. 2019 Nov 30;34:100622.
- Browne, H., Forster, S., Anonye, B. et al. Culturing of ‘unculturable’ human microbiota reveals novel taxa and extensive sporulation. Nature 533, 543–546 (2016).
- Diakite A, Dubourg G, Dione N, Afouda P, Bellali S, Ngom II, Valles C, Tall ML, Lagier JC, Raoult D. Optimization and standardization of the culturomics technique for human microbiome exploration. Sci Rep. 2020 Jun 15;10(1):9674.
- Fleming, E., Pabst, V., Scholar, Z. et al. Cultivation of common bacterial species and strains from human skin, oral, and gut microbiota. BMC Microbiol 21, 278 (2021).
- Forster, S.C., Kumar, N., Anonye, B.O. et al. A human gut bacterial genome and culture collection for improved metagenomic analyses. Nat Biotechnol 37, 186–192 (2019).
- Guilhot, E., Khelaifia, S., La Scola, B., Raoult, D., & Dubourg, G. (2018). Methods for Culturing Anaerobes from Human Specimen. Future Microbiology, 13(3), 369–381.
- Gutierrez C, Somoskovi A, Natarajan K, Bell D. Need for better adherence to optimal incubation temperature for quality laboratory diagnostics and antibiotic resistance monitoring. Afr J Lab Med. 2018 Dec 6;7(2):789.
- Huang, Y., Sheth, R.U., Zhao, S. et al. High-throughput microbial culturomics using automation and machine learning. Nat Biotechnol 41, 1424–1433 (2023). https://doi.org/10.1038/s41587-023-01674-2
- Ito, T., Sekizuka, T., Kishi, N., Yamashita, A., & Kuroda, M. (2018). Conventional culture methods with commercially available media unveil the presence of novel culturable bacteria. Gut Microbes, 10(1), 77–91.
- Lagier, J.-C.Maraninchi, M.Trape, J.-F.Koonin, E.V.La Scola, B. et al. Microbial culturomics: paradigm shift in the human gut microbiome study. Clinical Microbiology and Infection, Volume 18, Issue 12, 1185 - 1193 (2012).
- Lagier, JC., Khelaifia, S., Alou, M. et al. Culture of previously uncultured members of the human gut microbiota by culturomics. Nat Microbiol 1, 16203 (2016).
- Lau, J.T., Whelan, F.J., Herath, I. et al. Capturing the diversity of the human gut microbiota through culture-enriched molecular profiling. Genome Med 8, 72 (2016).
- Singhal N, Kumar M, Kanaujia PK, Virdi JS. MALDI-TOF mass spectrometry: an emerging technology for microbial identification and diagnosis. Front Microbiol. 2015 Aug 5;6:791.
- Tao X, Huang W, Pan L, Sheng L, Qin Y, Chen L, Yu L, Wu G, Wan J, Li H. Optimizing ex vivo culture conditions to study human gut microbiome. ISME Commun. 2023 Apr 25;3(1):38.
- Wade W. Unculturable bacteria--the uncharacterized organisms that cause oral infections. J R Soc Med. 2002 Feb;95(2):81-3.
- Zou, Y., Xue, W., Luo, G., et al. 1,520 reference genomes from cultivated human gut bacteria enable functional microbiome analyses. Nat Biotechnol 37, 179–185 (2019).
About the Author
Dorothy is a rising freshman at Northwestern University and recent Menlo School graduate, conducting summer biotechnology research under the guidance of Dr. Xin Zhou and Dr.Michael Snyder at the Stanford University School of Medicine. She is interested in the intersection of technology and medicine/biology.
Mentor: Dr. Xin Zhou. Affiliation: Stanford University